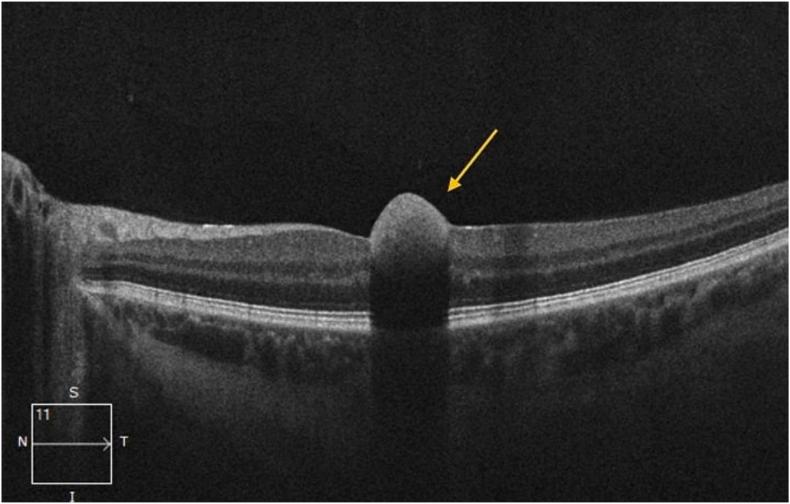
https://cdn.ncbi.nlm.nih.gov/pmc/blobs/e97b/12274723/bbeb799f93c8/gr2.jpg

贫血性视网膜病变作为纵隔生殖细胞肿瘤的首发症状。
Anemic retinopathy as the presenting symptom of a mediastinal germ cell tumor.
作者信息
Tallo Christian, Farris Paul, Farris Edmund
机构信息
University of Connecticut School of Medicine, Farmington, CT, USA.
Quinnipiac University Frank H. Netter MD School of Medicine, North Haven, CT, USA.
出版信息
Am J Ophthalmol Case Rep. 2025 Jun 27;39:102374. doi: 10.1016/j.ajoc.2025.102374. eCollection 2025 Sep.
PURPOSE
To describe a rare case of anemic retinopathy as the initial presenting symptom of a mediastinal germ cell tumor.
OBSERVATIONS
A 27-year-old male with no prior medical history presented with a one-day history of central vision loss in his left eye. Funduscopic evaluation showed a central macular hemorrhage in the left eye and bilateral nerve fiber layer hemorrhages and blot hemorrhages. Fluorescein angiography showed multiple hemorrhages without vascular occlusion or neovascularization, features indicative of anemic retinopathy. Laboratory evaluation demonstrated severe anemia (hemoglobin 6.7 g/dL), with an otherwise unremarkable metabolic and coagulation profile. Given these findings, an underlying hematologic or oncologic disorder was suspected, prompting further systemic evaluation. Imaging revealed a large anterior mediastinal mass, and biopsy confirmed a nonseminomatous germ cell tumor. The patient underwent chemotherapy with cisplatin, etoposide, and bleomycin, later transitioning to VIP (ifosfamide, etoposide, and cisplatin) due to suspected pulmonary toxicity. Patient responded well to treatment; his anemia gradually improved, and alpha-fetoprotein levels significantly declined. Following treatment, the patient reported no ongoing visual disturbances.
CONCLUSIONS AND IMPORTANCE
Anemic retinopathy can be the initial presentation of an underlying malignancy. Recognizing ophthalmologic findings as potential indicators of systemic disease is critical for early diagnosis and timely intervention in cases of occult malignancies.
目的
描述一例罕见的贫血性视网膜病变作为纵隔生殖细胞肿瘤的首发症状。
观察结果
一名27岁无既往病史的男性,因左眼中心视力丧失1天就诊。眼底检查显示左眼黄斑中心出血以及双侧神经纤维层出血和点状出血。荧光素血管造影显示多处出血,无血管阻塞或新生血管形成,这些特征提示贫血性视网膜病变。实验室检查显示严重贫血(血红蛋白6.7 g/dL),代谢和凝血指标其他方面均无异常。基于这些发现,怀疑存在潜在的血液系统或肿瘤性疾病,遂进行进一步的全身评估。影像学检查发现前纵隔有一个大肿块,活检证实为非精原细胞瘤性生殖细胞肿瘤。患者接受了顺铂、依托泊苷和博来霉素化疗,后因怀疑有肺部毒性而改用VIP方案(异环磷酰胺、依托泊苷和顺铂)。患者对治疗反应良好;贫血逐渐改善,甲胎蛋白水平显著下降。治疗后,患者报告无持续的视觉障碍。
结论与意义
贫血性视网膜病变可能是潜在恶性肿瘤的首发表现。将眼科检查结果视为全身疾病的潜在指标,对于隐匿性恶性肿瘤的早期诊断和及时干预至关重要。